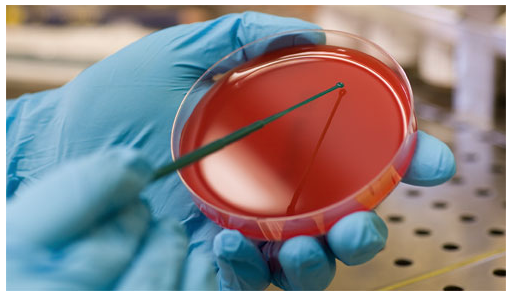

보이지 않으면 믿을 수 없다?
어떤 사람들은 보이는 것만 믿을 수 있고 보이지 않으면 믿을 수 없다라고 말합니다.
그래서 "하나님도 눈에 보이지 않기 때문에 믿을 수 없다"고 주장합니다.
하지만 우리가 가만히 주변을 살펴보고 생각해 보더라도 이 주장은 잘못된 주장이라는 것을
쉽게 이해 할 수 있습니다.
먼저 지구의 자전과 공전 입니다.
지구는 엄청난 속도로 자전과 공전을 합니다.
하지만 그것을 직접 보거나 움직이는 속도를 느끼고 있는 사람은 없습니다.
그저 과학자들의 간접적인 증거로 믿고 설명을 할 뿐이죠.
다음은 미생물 입니다.
작은 미생물을 우리 눈으로 보기에 매우 어렵지요~
그래서 현미경을 통해서 제한적으로 볼 수 있지요.
다음은 멀리 떨어져 있는 우주세계 입니다.
마찬가지로 사람의 눈으로 볼 수가 없지요~
그래서 망원경을 통해서 제한적으로 관찰하고 연구하고 있지요.
이처럼 우리는 제한된 세계에 살고 있으면서 마치 모든 것을 다 아는 것처럼 단정할 수 있을까요?
하나님께서 계시지 않는다고 할 수 있을까요?
그것은 자신의 어리석음을 스스로 나타내는 것에 불과합니다.
어리석은 자는 그 마음에 이르기를 하나님이 없다 하도다...
- 시편 53:1-
그러면 하나님의 존재를 우리는 무엇으로 확실히 믿고 이해 할 수 있을까요?
바로 성경입니다.
성경이 바로 영적 현미경이나 망원경의 역할을 해주는 것입니다.
성경을 살펴보면 장래 일을 미리 예언하시고 그대로 이루시는
하나님께서 존재 하심을 확인할 수 있습니다.(사 41:21~23, 44:7, 요 14:29)
그러므로 단순히 눈에 보이지 않기 때문에 하나님을 믿을 수 없다는 생각과 주장을 하기보다
성경을 통해서 하나님에 대해 알아보아야 하겠습니다.
성경이 바로 구원자를 증거하는 책이기 때문입니다.